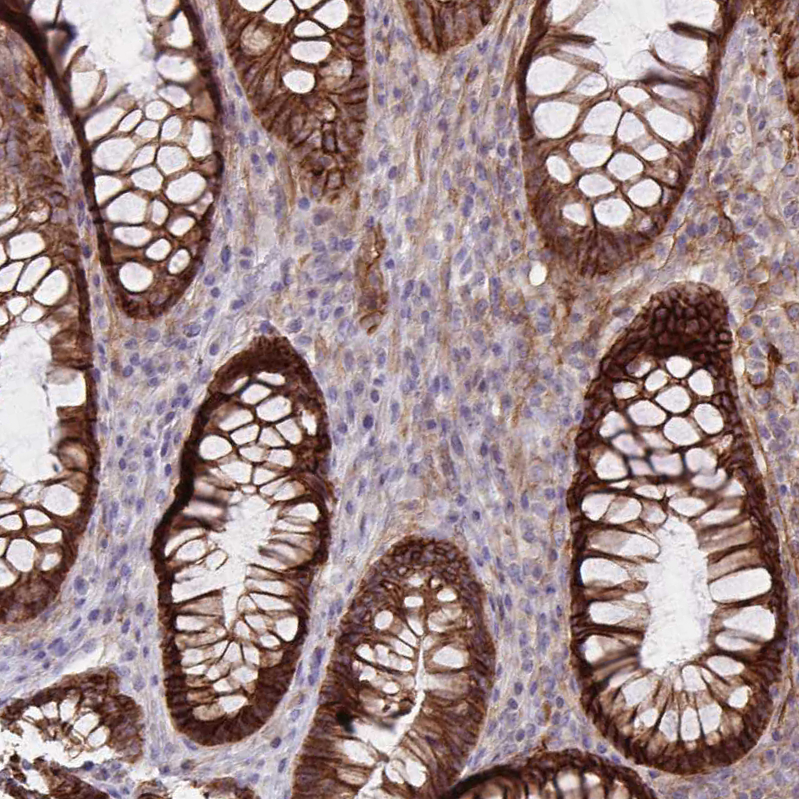

All products are designed for the highest possible performance and are manufactured using a standardized process to ensure the most rigorous levels of quality.
The Anti‑ITGA2 antibody (HPA063556) is an affinity‑purified rabbit polyclonal antibody targeting ITGA2/CD49B, the α2 subunit of the VLA‑2 integrin receptor - a key mediator of cell‑matrix adhesion through collagen and laminin binding. It is validated for IHC and WB, supported by orthogonal RNA‑seq and independent antibody validation (HPA060991), ensuring high specificity and reproducibility across human tissues. IHC analyses show strong membranous staining in integrin‑rich tissues such as skin, urinary bladder, rectum, and endometrium, with expected absence in hepatocytes. RNA‑seq data further confirms tissue‑specific expression, making this antibody a reliable tool for studying cell adhesion and extracellular‑matrix biology.
Significance in Research:
Cell‑Matrix Adhesion: ITGA2 pairs with β1 to form the α2β1 integrin complex, a major receptor for collagens, laminin, fibronectin, collagen C‑propeptides, and E‑cadherin, recognizing the G‑F‑P‑G‑E‑R motif and regulating adhesion, matrix remodeling, and mechanotransduction.
Platelet Function: α2β1 mediates platelet–collagen binding, contributing to hemostasis and thrombus formation.
Cancer Biology: ITGA2 is implicated in tumor invasion, stromal interaction, and extracellular‑matrix signaling, and is included in the Pan‑Cancer Atlas (18 cancer types).
Tissue Distribution: Enrichment in squamous epithelia, glandular tissues, and stromal regions aligns with its structural and adhesion‑related functions.
Alternative antibodies
Corresponding antigens
With Atlas Antibodies you get

From our facilities in Stockholm, Sweden we develop, manufacture and distribute highly advanced reagents to the Life Sciences community worldwide.

Our products are available to customers worldwide. From most locations, you can order our products from Atlas Antibodies. Please see more information about how to order here.

Learn how we validate our antibodies, how we secure their reproducibility, and why we apply enhanced validation. Our antibodies are validated in IHC, ICC-IF, and WB.